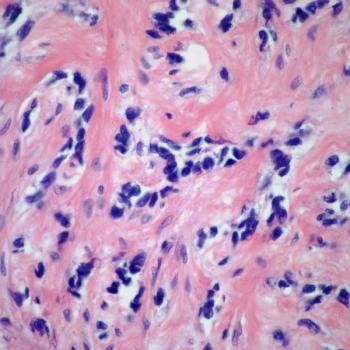

Sarcoma
Latest News
Latest Videos
CME Content
More News

The August CancerNetwork Snap Recap takes a look back at key FDA news updates, as well as expert perspectives on the chemotherapy shortage.

A planned phase 1 trial will examine CDK12/13 inhibitor CT7439 in patients with several types of solid tumors, including breast and ovarian cancer, as well as Ewing’s sarcoma.

Findings from a prospective study indicate that patients with undifferentiated pleomorphic sarcoma and leiomyosarcoma may present similarly to elderly patients with osteosarcoma.

Olaparib plus temozolomide appears to prolong median progression-free survival for those with homologous recombination deficient uterine leiomyosarcoma compared with homologous recombination proficient tumors.

Future developments in the sarcoma space may also involve research on circulating tumor DNA and metabolic therapies, according to Brian Van Tine, MD, PhD.

Current research in the sarcoma space includes the development of treatment options such as T-cell therapies, and combinations such as TKIs/immunotherapy, according to Brian Van Tine, MD, PhD.

The therascreen PDGFRA RGQ PCR kit has become the first FDA-approved companion diagnostic designed to detect platelet-derived growth factor receptor alpha gene mutations.

Brian Van Tine, MD, PhD, states that sitravatinib appears to be active and well tolerated among patients with dedifferentiated or well-differentiated liposarcoma.

Brian Van Tine, MD, PhD, also discusses how the treatment of desmoid tumors has evolved following data supporting the use of sorafenib in this population.

CAR T-cell therapies and immunotherapy agents may offer up new options and even become standard of care in certain sarcoma subtypes.

Brian Van Tine, MD, PhD, speaks about several agents and combination regimens that are currently under investigation in the sarcoma space, and potential next steps in research including immunotherapies and vaccine-based treatments.

Brian Van Tine, MD, PhD, discusses clinical trials assessing several regimens that may lead to novel treatment options for those with desmoid tumors, dedifferentiated liposarcoma, and other hard-to-treat sarcoma subtypes.
Sandra P. D’Angelo, MD, reviews current treatments in sarcoma, and how she interacts with her multidisciplinary counterparts to offer the best care to her patients.

The agent continues to produce ongoing responses in a cohort of patients with undifferentiated pleomorphic sarcoma or myxofibrosarcoma in the phase 2 ENVASARC trial.

Most adverse effects in a phase 2 trial related to doxorubicin appear to be expected in the treatment of patients with soft tissue sarcoma.

Cabozantinib plus nivolumab and ipilimumab appears to improve progression-free survival vs cabozantinib alone among patients with metastatic soft-tissue sarcoma in a phase 2 trial.

Nirogacestat also appears to improve progression-free survival compared with placebo among those with desmoid tumors in the phase 3 DeFi trial.

Manufacturers plan to halt further development of milademetan for liposarcoma following the publication of topline results from the phase 3 MANTRA trial.

A post hoc analysis indicates continuous intravenous infusion of doxorubicin does not yield additional benefit for patients with soft-tissue sarcoma compared with bolus delivery methods.

Findings from a phase 2 trial suggest that trabectedin plus radiotherapy is a tolerable treatment option in patients with myxoid liposarcoma despite yielding an unsatisfactory overall response rate.

An ancillary analysis of 2 clinical trials finds that pathologic complete response may be a prognostic factor of clinical outcomes in soft tissue sarcoma in future studies.

Patients with advanced well-differentiated/dedifferentiated liposarcoma may experience a positive progression-free rate following treatment with sitravatinib.

TP-1287 is under investigation as part of a phase 1 study in patients with metastatic or progressive solid tumors, including Ewing sarcoma, that are refractory or intolerant to other established therapies.

National Comprehensive Cancer Network guidelines will now include ripretinib as the ideal second-line treatment for patients with unresectable/metastatic gastrointestinal stromal tumors who are intolerant to sunitinib.

Nirogacestat may be a noteworthy therapeutic advance for patients with desmoid tumors, according to an expert from Memorial Sloan Kettering Cancer Center.








































